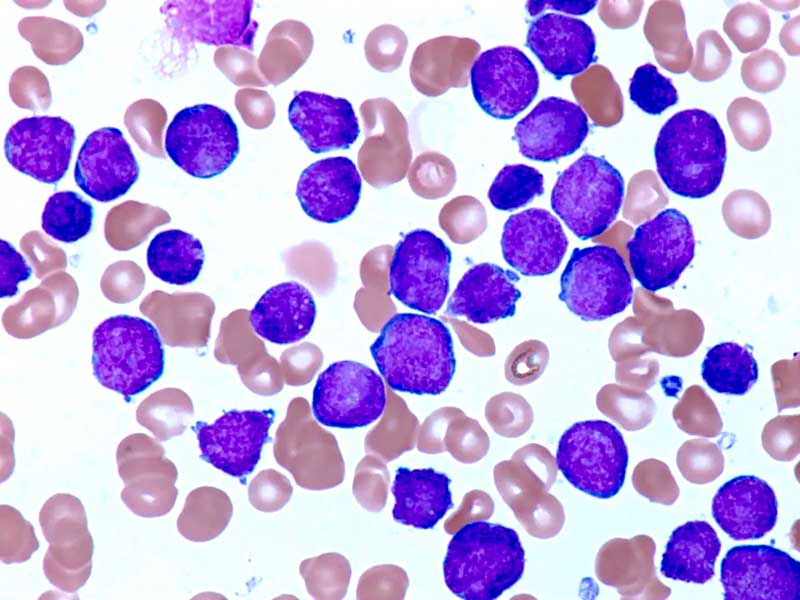

Muitos adultos mais velhos com leucemia linfoblástica aguda precursora de células B (BCP-ALL) têm recidiva, apesar da remissão completa para doença residual mínima (MRD) negativa com quimioterapia combinada. A adição de blinatumomabe à quimioterapia resultou em benefício significativo de sobrevida global (HR 0,41) nessa população de pacientes, como revela análise atualizada de Mark Litzou e colegas, em artigo na New England Journal of Medicine. A SG em 3 anos foi de 85% vs. 68%, favorecendo o grupo tratado com blinatumomabe versus o grupo de QT de consolidação isoladamente.
Neste estudo de fase 3 (NCT02003222), com participação de pesquisadores do ECOG-ACRIN Cancer Research Group e do Canadian Cancer Trials Group, foram inscritos pacientes de 30 a 70 anos de idade com BCP-ALL BCR::ABL1 negativa (com :: indicando fusão) que tiveram remissão negativa para Doença Residual Mínima mensurável (MRD, na sigla em inglês, definida como <0,01% de células leucêmicas na medula óssea, avaliada por citometria de fluxo), após quimioterapia de indução e intensificação. Os pacientes elegíveis foram randomizados para receber quatro ciclos de blinatumomabe além de quatro ciclos de quimioterapia de consolidação, ou para receber quatro ciclos de quimioterapia de consolidação isoladamente. O endpoint primário foi a sobrevida global; a sobrevida livre de recidiva foi um endpoint secundário.
A remissão completa com ou sem recuperação total da contagem foi observada em 395 de 488 pacientes inscritos (81%). Dos 224 pacientes com status negativo para MRD, 112 foram designados para cada grupo. Em um seguimento mediano de 43 meses, uma vantagem foi observada no grupo blinatumomabe em comparação com o grupo de quimioterapia em relação à sobrevida global (em 3 anos: 85% vs. 68%; razão de risco para morte, 0,41; intervalo de confiança [IC] de 95%, 0,23 a 0,73; P = 0,002). Os autores descrevem que a sobrevida livre de recidiva em 3 anos foi de 80% com blinatumomabe e de 64% com quimioterapia isoladamente (razão de risco para recidiva ou morte, 0,53; IC de 95%, 0,32 a 0,87).
Em relação à segurança, maior incidência de eventos neuropsiquiátricos foi relatada no grupo blinatumomabe
Em conclusão, os resultados de longo prazo relatados por Litzou et al. mostram que a adição de blinatumomabe à quimioterapia de consolidação em pacientes adultos com BCP-ALL em remissão MRD-negativa melhorou significativamente a sobrevida global.
Este estudo foi financiado pelo National Cancer Institute (NCI) dos Estados Unidos.
Referência:
N Engl J Med 2024;391:320-333
DOI: 10.1056/NEJMoa2312948